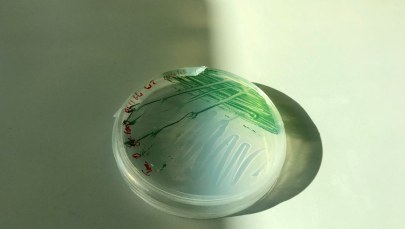
Fotosynteza starsza o... miliard lat

Po zakwicie sinic zamknięto większość kąpielisk nad otwartym morzem w woj. pomorskim. Sanepid podkreśla, że sytuacja jest dynamiczna: kąpieliska mogą zostać otwarte jeszcze tego samego dnia, a inne, jeśli pojawią się sinice, będą zamykane.
Z informacji Wojewódzkiej Stacji Sanitarno-Epidemiologicznej (WSSE) w Gdańsku wynika, że zakaz wchodzenia do wody, spowodowany wykwitem sinic, obowiązuje na kilkunastu kąpieliskach położonych nad otwartym morzem w pasie wybrzeża pomiędzy Jastarnią a Dębkami. Wciąż otwarte są natomiast kąpieliska w Kuźnicy, Juracie i Helu.
Zastępca dyrektora gdańskiej WSSE Anna Obuchowska podkreśliła w rozmowie z PAP, że sytuacja w każdej chwili może się zmienić. Wiatr i prądy morskie powodują, że skupiska sinic mogą szybko się przemieszczać. Wyjaśniła, że jeszcze w czwartek niektóre z zamkniętych kąpielisk mogą zostać otwarte. W innych miejscach natomiast, w każdej chwili może zostać ogłoszony zakaz kąpieli.
Ratownicy na poszczególnych kąpieliskach obserwują wodę i to oni - w zależności od jej stanu - podejmują decyzję o ich zamknięciu lub otwarciu - podkreśliła Obuchowska.
WSSE przypomina, że w przypadku obfitego zakwitu sinic, stacja zaleca absolutny zakaz wchodzenia do wody. Kąpiel w zanieczyszczonej sinicami wodzie może spowodować niekorzystne reakcje organizmu: od wysypek na skórze po zaczerwienienie spojówek. W przypadku połknięcia takiej wody mogą wystąpić dolegliwości ze strony układu pokarmowego w tym m.in. biegunka, wymioty i bóle brzucha.
Jak przypomina na swojej stronie internetowej organizacja ekologiczna WWF Polska, wiosenny i wczesnoletni zakwit sinic jest zjawiskiem naturalnym. Jednak - w opinii organizacji - skala tego zjawiska w wodach Bałtyku z roku na rok jest coraz większa. Jak przypomina WWF, zakwit sinic sprawia, że woda staje się mętna i zaczyna przypominać cuchnącą zupę. Może mieć brązowawy, czerwonawy, zielonawy bądź żółtawy kolor - wyjaśniają ekolodzy. Dodają, że zakwit sinic zależy od stężenia w wodzie składników organicznych - związków azotu i fosforu.
Kiedy zdarza się za często i sinic jest bardzo dużo, może to prowadzić do zamierania życia w Morzu Bałtyckim. Rozkład obumarłych sinic pochłania dużo tlenu. To najczęściej z jego braku giną ryby i inne organizmy występujące w morzu - podaje WWF na swojej stronie internetowej. Jednocześnie dodaje, że szczególnie niebezpieczne są toksyczne gatunki sinic, które mogą zabijać ryby, ptaki i ssaki, a ponieważ wydzielają toksyny, szkodzą także ludziom. Nawet po zakończeniu zakwitu sinic wytwarzane przez nie toksyny pozostają przez pewien czas w wodzie - dodają ekolodzy.
(az)